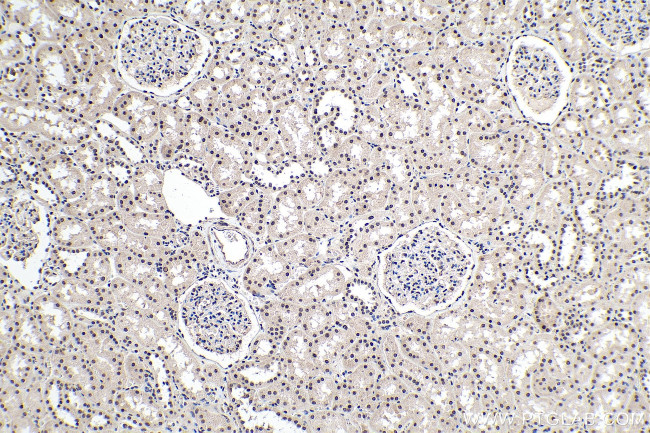
PDGFC Antibody in Immunohistochemistry (Paraffin) (IHC (P))

Search
Proteintech
PDGFC Polyclonal Antibody
{{$productOrderCtrl.translations['antibody.pdp.commerceCard.promotion.promotions']}}
{{$productOrderCtrl.translations['antibody.pdp.commerceCard.promotion.viewpromo']}}
{{$productOrderCtrl.translations['antibody.pdp.commerceCard.promotion.promocode']}}: {{promo.promoCode}} {{promo.promoTitle}} {{promo.promoDescription}}. {{$productOrderCtrl.translations['antibody.pdp.commerceCard.promotion.learnmore']}}
产品信息
55076-1-AP
种属反应
宿主/亚型
分类
类型
抗原
偶联物
形式
浓度
规格
纯化类型
保存液
内含物
保存条件
运输条件
靶标信息
Sphingosine Kinase 2 (Sphk2) catalyzes the phosphorylation of sphingosine to sphingosine 1 phosphate (S1P), an important signaling molecule with intra- and extracellular functions. Inside the cell S1P acts as a signaling molecule like other sphingolipid metabolites like ceramide and sphingosine. S1P has been implicated in regulating cell differentiation, calcium mobilization from intracellular stores, and apoptosis. The cell surface receptors for S1P are the EDG family of G protein-coupled receptors (S1P Receptors).These receptors couple to multiple G proteins (e.g. S1P1 couples to Gi whereas S1P2 and S1P3 couple to Gq, G13 in addition to Gi) and regulate a extremely wide range of cellular events including cell motility, survival, apoptosis, migration and cellcell interaction. Important roles for S1P have also been reported in regulation of cardiogenesis, vascular maturation, oocyte survival, immune cell trafficking, cells of the neuronal system and bone cells. S1P levels are regulated by the activity of Sphk (Sphk1 and Sphk2).
仅用于科研。不用于诊断过程。未经明确授权不得转售。
生物信息学
蛋白别名: C76851; Fallotein; MGC102297; PDGF-C; PDGF-C; ZVEGF3; Platelet-derived growth factor C; SCDGF; secretory growth factor-like protein; Spinal cord-derived growth factor; unnamed protein product; VEGF-E
基因别名: 1110064L01Rik; AI647969; FALLOTEIN; PDGF-C; PDGFC; SCDGF; UNQ174/PRO200
UniProt ID: (Human) Q9NRA1, (Mouse) Q8CI19
Entrez Gene ID: (Human) 56034, (Mouse) 54635